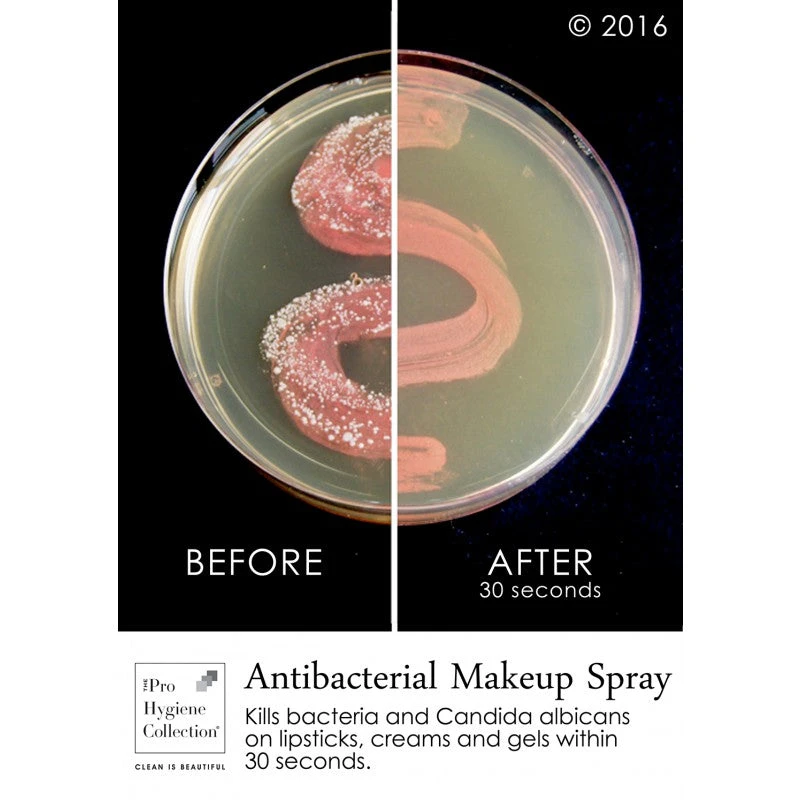
The Pro Hygiene Collection - Antibacterial Makeup Spray(The Pro Hygiene Collection Antibacterial Makeup Spray) 4 The Pro Hygiene Collection - Antibacterial Makeup Spray(The Pro Hygiene Collection Antibacterial Makeup Spray) - Image 2

The Pro Hygiene Collection – Antibacterial Makeup Spray(The Pro Hygiene Collection Antibacterial Makeup Spray)
£12.00 Original price was: £12.00.£8.40Current price is: £8.40.
SKU: DGLSD 3654848446544 Categories: BEAUTY, CHEEKS Tags: Alcohol, Covid-19, Hand sanitiser, Sanitiser
- Uncompromising quality, every time.
- Safe and Secure Payments, Always
- 7 days return and exchange
- Shop with confidence, we guarantee quality.

The Pro Hygiene Collection Antibacterial Makeup Spray safely eliminates bacteria from makeup and hard beauty tools and accessories. It sanitizes makeup and hard beauty tools and kills 99.99% of bacteria within 60 seconds without affecting makeup performance. Quick and easy to use on:
- pressed and loose powders
- pigments
- gels and creams
- lipsticks
- pencils
- false eye lashes
- hard tools and accessories (tweezers, eye lash curlers etc)
The Pro Hygiene Collection Antibacterial Makeup Spray prevents regrowth of bacteria between uses. Cruelty-free and vegan-friendly. Made in the UK.
| Size | 15ml, 100ml |
|---|
Be the first to review “The Pro Hygiene Collection – Antibacterial Makeup Spray(The Pro Hygiene Collection Antibacterial Makeup Spray)” Cancel reply
Related products
Sale!
Sale!
Sale!
Sale!
Sale!
Sale!
Sale!
Sale!

Reviews
There are no reviews yet.